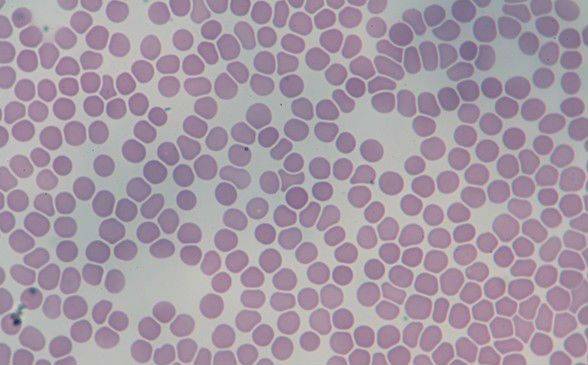

Эритроциты
Эритроциты называются красными кровяными тельцами. Это самая многочисленная группа клеток. Они переносят кислород от органов дыхания к тканям и принимают участие в транспортировке углекислого газа от тканей к легким.
Место образование эритроцитов – красный костный мозг. Живут они 120 дней и разрушаются в селезенке и печени.
Образуются из клеток-предшественниц – эритробластов, которые перед превращением в эритроцит проходят разные стадии развития и несколько раз делятся. Таким образом, из эритробласта образуется до 64 красных кровяных клеток.

Эритроциты лишены ядра и по форме напоминают вогнутый с двух сторон диск, диаметр которого в среднем составляет около 7-7,5 мкм, а толщина по краям – 2,5 мкм. Такая форма способствует увеличению пластичности, необходимой для прохождения по мелким сосудам, и площади поверхности для диффузии газов. Старые эритроциты утрачивают пластичность, из-за чего задерживаются в мелких сосудах селезенки и там же разрушаются.
Большая часть эритроцитов (до 80 %) имеет двояковогнутую сферическую форму. Остальные 20 % могут иметь другую: овальную, чашеобразную, сферическую простую, серповидную и пр. Нарушение формы связано с различными заболеваниями (анемией, дефицитом витамина B12, фолиевой кислоты, железа и др.).
Большую часть цитоплазмы эритроцита занимает гемоглобин, состоящий из белка и гемового железа, которое придает крови красный цвет. Небелковая часть представляет собой четыре молекулы гема с атомом Fe в каждой. Именно благодаря гемоглобину эритроцит способен переносить кислород и выводить углекислый газ. В легких атом железа связывается с молекулой кислорода, гемоглобин превращается в оксигемоглобин, придающий крови алый цвет. В тканях гемоглобин отдает кислород и присоединяет углекислый газ, превращаясь в карбогемоглобин, в результате кровь становится темной. В легких углекислый газ отделяется от гемоглобина и выводится легкими наружу, а поступивший кислород вновь связывается с железом.
Кроме гемоглобина, в цитоплазме эритроцита содержатся различные ферменты (фосфатаза, холинэстеразы, карбоангидраза и др.).
Оболочка эритроцита имеет достаточно простое строение, по сравнению с оболочками других клеток. Она представляет собой эластичную тонкую сетку, что обеспечивает быстрый газообмен.
На поверхности красных кровяных клеток находятся антигены разных видов, которые определяют резус-фактор и группу крови. Резус-фактор может быть положительным или отрицательным в зависимости от присутствия или отсутствия антигена Rh. Группа крови зависит от того, какие антигены находятся на мембране: 0, A, B (первая группа – 00, вторая – 0A, третья – 0B, четвертая – AB).
В крови здорового человека в небольших количествах могут быть недозрелые эритроциты, которые называются ретикулоцитами. Их количество увеличивается при значительной кровопотере, когда требуется возмещение красных клеток и костный мозг не успевает их производить, поэтому выпускает недозрелые, которые тем не менее способны выполнять функции эритроцитов по транспортировке кислорода.
Эритроциты
Пожалуй, главную задачу крови выполняют именно эритроциты — красные кровяные тельца, основная функция которых — транспорт кислорода и углекислого газа. 300 лет назад их называли «красными кровяными шариками», впервые они были найдены не в крови человека, а лягушки.
Позже, известный биолог А. Левенгук обнаружил их и в человеческой крови. Долгое время люди пребывали в полном неведении относительно функций этих клеток, и только в девятнадцатом веке ученые смогли выяснить назначение эритроцитов.

Строение красных кровяных телец
Чтобы наиболее эффективно выполнять свое предназначение, эритроциты должны:
- Иметь наибольшую площадь своей поверхности.
- Содержать в себе как можно больше гемоглобина.
- Проходить через самые мелкие сосуды.
Все эти пункты клетки выполняют благодаря своей необычному телу. В отличие от заблуждений прошлых веков, эритроциты имеют вовсе не шарообразную форму – тело кровяной клетки представляет собой двояковогнутый диск, то есть приплюснутый посредине. Благодаря такой форме, достигается увеличение площади поверхности клетки относительно ее объема (по сравнению с шаром).

Строение эритроцита
Также дисковидная форма помогает этим клеткам сворачиваться «в трубочку» при продвижении по мельчайшим сосудам. И хотя диаметр обычного эритроцита составляет примерно 8 мкм, он способен, «свернувшись», пройти в капилляр диаметром до 2-3 мкм.
Для максимального насыщения эритроцита гемоглобином многие органоиды или вовсе не присутствуют (как ядро), или представлены в малом количестве. Гемоглобин составляет 90% сухого вещества красных кровяных телец. Эритроциты содержат в своем теле такое большое количество гемоглобина из-за его способностей:
- При избытке в среде кислорода (то есть в легких) гемоглобин способен присоединять его к себе, превращаясь в оксигемоглобин. Он окрашивает насыщенную кислородом кровь в алый цвет.
- В тканях с низким содержанием кислорода белок отщепляет от себя кислород в окружающую среду.
Жизнь и смерть эритроцитов
Процесс кроветворения, итогом которого является эритроцит, получил название эритропоэз. Все клетки крови происходят из особого класса стволовых клеток костного мозга. В результате деления стволовой клетки одна клетка будет сохранять ее свойства, а другая с каждым последующим делением будет приобретать все более характерные для зрелых клеток качества.

Эритропоэз
Принципиально важно, что из стволовых клеток могут образовываться предшественники любых клеток крови, а из их близких потомков – унипотентых клеток – предшественницы только одного вида. При дальнейшем делении из простых близких потомков получаются морфологически распознаваемые клетки, их называют кроветворными ростками или клетками предшественниками
Эритробласт (первая стадия бласты) имеет ядро. Они способны к делению (в отличие от эритроцитов, не имеющих ядра), поэтому образуют большое количество клеток следующего поколения – проэритробласт. Их основная задача заключается в созревании, которое выражается в синтезе и накоплении гемоглобина.
После нескольких промежуточных стадий будущий эритроцит становится метарубрицитой: именно на этой стадии развития клетка будет избавляться от лишних органоидов. Следующая ступень взросления эритроцита получила имя ретикулоцит или «юный эритроцит». На этой стадии клетки выходят из костного мозга и попадают в общее кровеносное русло, они еще имеют «сеточку» из самопереваренных органоидов, но после 30-45 часов полностью избавятся от остатков и превратятся в зрелых эритроцитов.
В среднем, эритроциты живут 3-4 месяца, продолжительность жизни определяется способностью проходить через мелкие сосуды (при старении теряется прежняя пластичность и клетка становится более жесткой). Если клетка неспособна выполнять свою функцию, она разрушается. Тогда за дело берутся макрофаги (один из видов лейкоцитов), расположенные на внутренней поверхности сосудов – они заглатывают эритроцитов.
Больше всего красных кровяных телец гибнет в селезенке, она является своеобразным пунктом проверки качества из-за своего строения – селезенка содержит большое количество очень узких капилляров. Помимо селезенки, эритроциты погибают в костях, в печени и просто в сосудистом русле.
Роль эритроцитов в организме
Первостепенная задача эритроцитов – снабжение всех частей организма кислородом и обратный перенос углекислого газа от органов к легким. По сути, это единственная функция эритроцитов – особенности их строения и химического состава не позволяют выполнять еще какие-либо другие задачи.
Тромбоциты
Эти клетки по форме напоминают пластинки небольших размеров. Они образуются из гигантских клеток – мегакариоцитов, которые находятся в костном мозге. В этих клетках нет ядра, но есть множество гранул. Когда тромбоцит сталкивается с участком повреждения в стенке сосуда, он начинает прижиматься к нему отростками и зазубринами. Этот механизм помогает остановить кровотечение. У обычного человека число тромбоцитов в норме колеблется в пределах 200 – 400 тысяч в 1 мкл. У женщин этот показатель несколько меньше, особенно в периоды менструальных кровотечений.
Снижение числа тромбоцитов называется тромбоцитопенией, а увеличение – тромбоцитозом. В обычных условиях физиологический рост этих клеток может происходить при боли, стрессе или чрезмерной физической нагрузке. При патологии увеличение числа тромбоцитов возникает после спленэктомии (удаления селезенки) или при болезнях костного мозга.
Основная роль тромбоцитов – это поддержание гемостаза и остановка кровотечения. В гранулах и на мембране этих клеток сосредоточены специальные тромбоцитарные факторы, благодаря которым возможно образование тромбов и пломбировка участка поврежденного сосуда. Кроме этого, они обладают фагоцитарной активностью и защищают организм от болезнетворных агентов наряду с лейкоцитами.
https://youtube.com/watch?v=YxcrkL_-teI
Колебания уровня лейкоцитов
Отклонение от нормы содержания белых кровяных клеток свидетельствует о воспалении, даже в случае незначительного по масштабам процесса клетки оперативно борются с проблемой. Повышенные показатели способны спровоцировать следующие факторы:
- Переедание,
- Введение вакцины,
- Менструация у женщин,
- Ранки на коже.
Повышенные лейкоциты наблюдаются, как правило, при заболеваниях внутренних органов, онкологических патологиях, инфекциях, в послеоперационном периоде. Понижение же отмечается при вирусных инфекциях, авитаминозе, приеме некоторых лекарственных средств, снижении иммунитета.
Уровень нейтрофилов – одной из разновидностей лейкоцитов – практически всегда меняется, когда организм защищается от инфекций. Кроме этого, повышение уровня этих клеток происходит при:
- Травмах,
- Остеомиелите,
- Воспалительных процессах во внутренних органах,
- Диабете,
- Вакцинации,
- Опухолях,
- Приеме препаратов для поддержания иммунной системы.
Стоит помнить, что содержание красных и белых кровяных телец должно соответствовать норме. При обнаружении изменений в результатах анализов нужно выявить причину, породившую отклонение, и направить все усилия на устранение проблемы. Ведь плохой анализ — не шутка, а зачастую первый «звоночек» о неполадках в организме.
Другие анализы крови
Также выполняется биохимия крови, в ходе которой оценивается состав плазмы, а именно: глюкоза, мочевина, креатинин, белок, электролиты (калий, натрий, хлор), холестерин, триглицериды, билирубин, амилаза и др. Другие исследования определяют уровень ферментов, гормонов, белков или микроэлементов в организме. Выполнение биохимических анализов крови дает представление о функционировании практически всех органов организма. Огромное количество состояний не может быть диагностировано и вылечено без оценки изменений в крови этих веществ.
Различные лаборатории могут устанавливать свои стандарты, немного отличающиеся друг от друга, всегда принимая во внимание область применения лабораторного стандарта, выполняющего исследование. Следует помнить, что не каждое отклонение от нормы является болезнью, и не каждый нормальный результат морфологии крови указывает на отличное здоровье
Стандарты лабораторных исследований зависят от многих факторов и не должны рассматриваться изолированно от других элементов диагностического процесса.
Вышеуказанная статья является лишь общим описанием информации, связанной с анализом крови. Приведены только примеры болезненных состояний, связанных с аномальными результатами анализа крови. Представленные здесь данные носят исключительно информационный характер и не могут заменить профессиональную медицинскую консультацию. В случае проблем со здоровьем и каких-либо сомнений, обратитесь к врачу за советом. Только медицинская консультация, основанная на личном осмотре пациента, истории болезни и дополнительных анализах, всегда гарантирует безопасное лечение, которое может дать желаемый положительный эффект для здоровья.
Функции эритроцитов и лейкоцитов
Эритроциты – главные элементы крови. Они зарождаются в красном костном мозге и разрушаются в селезенке и печени. Клетки имеют форму двояковогнутого диска, они эластичны, поэтому способны протискиваться даже в мельчайшие капилляры. Эритроциты в крови окрашены в красный цвет. Это связано с содержанием в них белка гемоглобина, главный компонент которого – железо, в отличие от лейкоцитов, в котором этого составляющего нет. Насыщенно красный цвет крови эритроциты приобретают на зрелой стадии развития, когда они насытились гемоглобином. В ином случае окрас клеток синий.
Один из основных элементов крови — эритроциты
У человека красные кровяные тельца не имеют оформленных ядер и органоидов. Снаружи эритроцит покрыт клеточной эластичной мембраной, которая способна пропускать газ, воду, ионы водорода и глюкозу.
Диаметр клеток приравнивается к 7 мкм, толщина – 2 мкм. У женщин норма содержания эритроцитов – 3,7·1012/л. — 4,7·1012/л., у мужчин – 4,5·1012/л. — 5,5·1012/л. Но данный показатель может варьироваться в зависимости от множества факторов: возраста, физической активности, физиологических особенностей, психологических нагрузок и иных внешних факторов.
Главная функция эритроцитов состоит в том, что они переносят кислород от легких к тканям и органам и выводят углекислый газ, то есть участвуют в клеточном дыхании. Задача выполняется благодаря гемоглобину, который проходит через капилляры легких. При этом гемоглобин образует соединение с кислородом и превращается в оксигемоглобин, который затем расщепляется в органах, вырабатывая при этом кислород.
Далее белок, освобожденный от кислорода, поглощает углекислый газ, выводя его из организма. Продолжительность жизни клеток составляет порядка 120 дней. В течение дня разрушается 200 млрд. красных кровяных клеток и столько же образуется. В общей сложности в организме человека 25 трлн эритроцитов, если развернуть их в цепочку, ее протяженность составит 200000 км. Площадь эритроцитов, которые участвуют в газообмене, тоже очень велика – 3200 кв. м.
Лейкоциты – бесцветные кровяные клетки. Из-за отсутствия окраски их называют белыми кровяными клетками. В отличие от эритроцитов, лейкоциты содержат все клеточные структуры: ядро, органоиды, цитоплазму, они способны самостоятельно перемещаться и выходить в межклеточное пространство, проникая через капиллярную стенку, эритроциты же отличаются от лейкоцитов еще тем, что движутся только с током крови.
Белые клетки тоже образуются в красном костном мозге и выполняют преимущественно защитную функцию. При кожных повреждениях лейкоциты направляются к месту поражения, защищая рану от попадания болезнетворных микроорганизмов.
Одни лейкоциты выделяют вещества, из-за которых «чужеродные гости» гибнут, другой вид набрасывается на них и поглощает. Процесс защиты – фагоцитоз – заключается в переваривании клеток, а лейкоциты пожиратели называются фагоцитами.
Лейкоцитарные клетки, в частности, лимфоциты, играют важную роль в формировании специфического иммунитета.
Клетки без гемоглобина именуют белыми кровяными тельцами или лейкоцитами
Лейкоцитарная норма для взрослого человека – 4 × 109 – 8,51 × 09/л. Но показатели не абсолютны, все зависит от времени суток и состояния здоровья человека. Уровень белых клеток немного повышается после приема пищи, физических нагрузок, эмоциональных переживаний, а также при воспалительных процессах в организме.
Колебания уровня белых и красных клеток крови
В зависимости от наличия патологических либо физиологических факторов концентрации лейкоцитов и эритроцитов в крови могут значительно колебаться, как в сторону увеличения, так в сторону уменьшения.
Эритроциты
Относительными нормами содержания эритроцитов в крови является диапазон значений от 3,8 до 5,2* 1012 степени компонентов на 1 литр крови. Незначительное увеличение их числа может быть связано с приемом диуретиков, обильные диареи либо же последствия ожог. Сверхнормированная концентрация эритроцитов называется эритроцитозом и может формироваться в следующих случаях:
- Разнообразные новообразования, как доброкачественной, так и злокачественной природы;
- Прием ударных доз кортикостероидов;
- Синдром Кушинга на любой стадии;
- Истинная полицитемия;
- Длительное системное лечение стероидами;
- Водянка почечных лоханок.
Уменьшение концентрации эритроцитов в крови по отношению к нормам может вызываться следующими обстоятельствами:
- Беременность на поздних стадиях;
- Различные формы анемии;
- Средняя либо сильная кровопотеря;
- Системная инфузионная терапия с регулярным введением кровотока большого количества жидкости;
- Различные заболевания и патологии, связанные с ускоренным разрушением клеток, а также снижением интенсивности их образования в костном мозге.
Лейкоциты
Относительными нормами содержания лейкоцитов в крови является диапазон от 4 до 8*109 форменных элементов на 1 литр биологической жидкости. Концентрация лейкоцитов сверх нормы называется лейкоцитозом и может вызываться следующими обстоятельствами (подробнее о повышенном уровне лейкоцитов в крови вы узнаете в этой статье):
- Беременность в рамках окончания последнего триместра развития плода, а также интенсивное кормление грудью;
- Ударные физические нагрузки на регулярной основе;
- Инфаркт миокарда любой стадии;
- Разнообразные травмы мягких тканей, гнойные процессы и сепсис;
- Острые воспалительные заболевания инфекционной природы, в частности вирусные, грибковые, бактериальные поражения;
- Отдельные аутоиммунные процессы системного характера.
Концентрация лейкоцитов ниже нормы (лейкопения) может указывать на следующие причины:
- Вирусные заболевания широкой этиологии;
- Аплазия и частичная деструкция костного мозга;
- Различные вариации тифа;
- Коллагенозы широкого спектра;
- Острые лейкозы, в том числе лучевая болезнь либо иные воздействия ионизирующего излучения;
- Миелофиброз и разнообразные миелодиспластические синдромы;
- Метастазирование в костный мозг;
- Гиперспленизм, как вторичной, так и первичный природы;
- Пернициозная анемия и плазмоцитома;
- Внешнее влияние при употреблении лекарственных препаратов и ряда веществ.
Причины пониженного уровня лейкоцитов в крови
Если при исследовании крови человека выявлено пониженное содержание лейкоцитов (лейкопения), это значит, в организме произошли сбои в функционировании. Данное отклонение от нормы не должно оставаться без внимания. Оно требует повторного и дополнительного обследования, которое выявит причины развития лейкопении. Они ложатся в основу дальнейшего лечения.
Причины лейкопении:
- наличие у человека ВИЧ-инфекции или СПИДа;
- аутоиммунные заболевания;
- нарушение работы печени;
- нарушения в работе эндокринной системы;
- сбои в работе желудочно-кишечного тракта;
- кишечные паразиты;
- раковые заболевания;
- плохая экология;
- · радиационное облучение;
- · метастазы во внутренних органах;
- заболевания, вызванные различными инфекциями. Во время борьбы с инфекционными заболеваниями происходит удаление лейкоцитов из крови и оседание их в пораженных местах;
- интоксикация организма;
- период после курса химиотерапии при онкологии;
- дефицит витаминов. Недостаток того или иного элемента возникает в связи с неправильным и неполноценным питанием. Это может вызвать изменение структуры крови.
Эритроциты, лейкоциты и тромбоциты
Эритроциты – это красные кровяные клетки, которые в организме выполняют дыхательную функцию: транспортируют кислород и углекислый газ по крови, а также регулируют содержание аминокислот и полипептидов в плазме (Б. И. Збарский). В 1 мм3 крови содержится 4-5,5 млн. эритроцитов. Они представляют собой двояковогнутый диск, окруженный мембраной. Местом образования эритроцитов является в основном костный мозг, а также селезенка и печень. Продолжительность жизни эритроцитов в циркулирующей крови составляет около 100 дней. Процесс созревания эритроцитов представляет собой сложный и сравнительно длительный процесс, когда из ядросодержащих клеток через стадии нормобластов, ретикулоцитов образуются эритроциты.
Из белков эритроцитов важнейшее значение принадлежит гемоглобину, содержание которого может доходить до 41%. Во всем количестве эритроцитов человека содержится примерно 800 г гемоглобина. В цельной крови количество гемоглобина составляет 13-18 г%. В настоящее время обнаружены различные формы гемоглобинов, отличающиеся по аминокислотному составу глобина – его белковой части. У эмбрионов человека на 7-12-й неделе обнаружен примитивный гемоглобин (НbР), который в дальнейшем замещается фетальным (HbF). Последний составляет 70-90% всего гемоглобина детей. У взрослого человека основную массу гемоглобина составляет гемоглобин A1 (HbA1).
При некоторых заболеваниях (серповидноклеточная анемия, талассемия) в крови больных обнаруживаются патологические формы гемоглобинов, получивших обозначения С, D, S и др. Эти заболевания относятся к наследственной патологии, в основе которой лежит нарушение процесса синтеза глобина.
При повреждении мембраны эритроцита под действием измененного осмотического давления, различных токсинов гемоглобин выходит в плазму. Такой процесс называется гемолизом. Уменьшение в крови гемоглобина приводит к развитию различных анемий. Снижение гемоглобина до 5% ведет к смерти.
В клинике имеет большое значение определение количества гемоглобина крови. Его концентрация у взрослых людей варьируете пределах 13-18 г%, у ребенка после рождения составляет 19,5 г%, ко второму месяцу снижается до 11,5 г%.и постепенно достигает уровня взрослых людей к 12 годам.
В клинике существуют различные методы определения гемоглобина, из которых наиболее распространенным является метод Сали, когда после прибавления к крови соляной кислоты гемоглобин превращается в солянокислый гематин коричневого цвета и по сравнению его окраски с окраской стандартного раствора определяют концентрацию гемоглобина. Другим показателем, применяемым для анализа красных кровяных телец, является цветной показатель. Последний позволяет получить представление о содержании гемоглобина в эритроцитах, на чем основана клиническая классификация анемий. Реакция оседания эритроцитов (РОЭ) является одной из самых важных и широко распространенных лабораторных методов исследования. Сущность ее состоит в том, что кровь, стабилизированная какими-либо веществами, оставленная в вертикальном сосуде, через некоторое время просветляется за счет оседания эритроцитов и других форменных элементов крови. Как установлено, скорость оседания эритроцитов у здоровых людей приблизительно одинакова и составляет 5-10 мм в час. При уменьшении показателя А/Г (острая стадия ревматизма, злокачественные новообразования, почечные заболевания, анемии) РОЭ ускорена. При сердечных и печеночных заболеваниях РОЭ замедлена
В клинической практике важное значение придают также методам исследования гемостаза, свертывания крови, ломкости капилляров
Лейкоциты. В 1 мм3 крови содержится 5-6 тыс. белых кровяных телец. Они подразделяются на ряд форм в зависимости от формы ядра и способа окраски.
Лейкоциты участвуют в процессах фагоцитоза – захватывания и переваривания инородных тел и бактерий. В местах воспаления всегда много лейкоцитов, которые в своей массе образуют гной.
Тромбоциты. Это безъядерные клетки. В 1 мм3 крови их содержится 200-300 тыс. Тромбоциты участвуют в процессах свертывания крови.
Заключение
Лейкоциты – разнородная группа элементов крови, которые осуществляют защиту организма от внешних и внутренних заболеваний
Каждый вид белых клеток выполняет определенную функцию, поэтому важно, чтобы их содержание соответствовало норме. Любые отклонения могут указывать на развитие болезней
Анализ крови на лейкоциты позволяет на ранних этапах заподозрить патологию, даже если отсутствует симптоматика. Это способствует своевременной диагностике и дает больше шансов на выздоровление.
Кому я посоветую прочитать рассказ муму кратко
Как король отнесся к революции 1789 кратко
Что такое портьера кратко
Как русский костюм повлиял на мировую моду кратко
- Как заселяли и осваивали европейский север кратко география







![Эритроциты, лейкоциты и тромбоциты [1974 ермолаев м.в. - биологическая химия]](https://raznicynet.com/wp-content/uploads/6/5/8/658c1f76b564818e2ab62e9d38764837.jpeg)














![Эритроциты и лейкоциты [1982 цузмер а.м., петришина о.л. - человек. анатомия, физиология и гигиена]](https://raznicynet.com/wp-content/uploads/c/5/d/c5dbe40c4876938259ff6492a74d96cf.jpeg)







